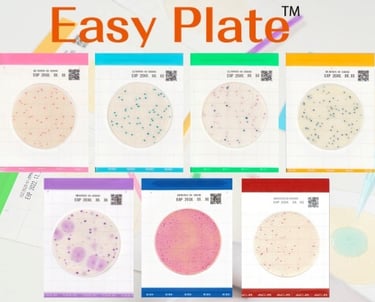
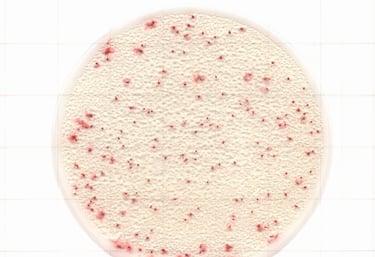
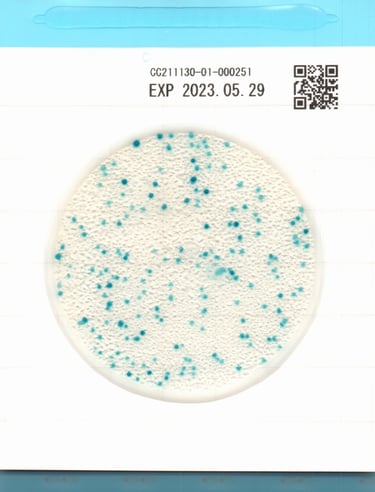
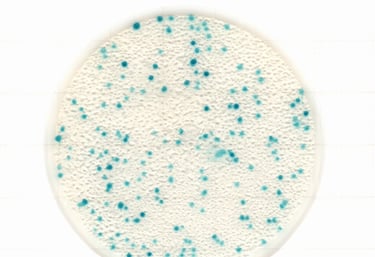
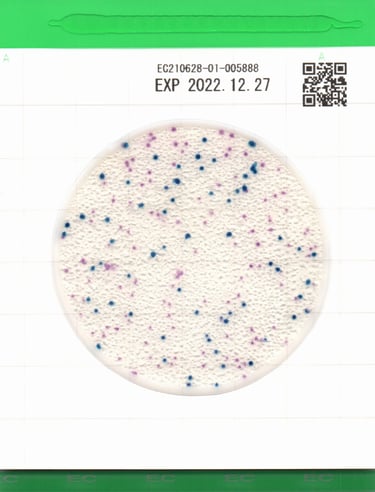
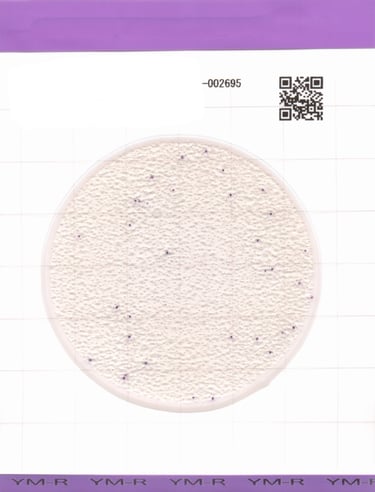

Prepared chromogenic Media
Easy Plate is a prepared media plates with no need for media preparation and sterilization. Using a time-tested and AOAC RI PTM, MicroVal and NordVal (AOAC RI PTM, MicroVal and NordVal cerification for Easy Plate EB and AC-R is pending.) validated culture media methodology, Easy Plate comes in an easy-to-use, stackable film plate format that saves on space, reduces waste, eliminates preparation time and labor, and streamlines your test procedures.

Microbial Detection Types
AC Plate
Object microorganism : Aerobic Bacteria
Incubation Temperature : 35±1℃
Incubation Time : 48±2 hours
Object microorganism : Coliform
Incubation Temperature : 35±1℃
Incubation Time : 24±1 hours
Easy Plate EC
Object microorganism: Ecoli./Coliform
Incubation Temperature: 35±1℃
Incubation Time: 24±1 hours
Easy Plate SA
Object microorganism: Staphylococcus aureus
Incubation Temperature: 35±1℃
Incubation Time: 24±1 hours
Easy Plate YM-R
Object microorganism: Yeast and Mold
Incubation Temperature: 35±1℃
Incubation Time: 48-72 hours
Get in touch
Address
HollyRock street , Muqablain , Amman-Jordan
Contacts
landline : 00962-4202737
Email : sales@jasmine-med.com
Mobile and whatsapp : 00962-777615302